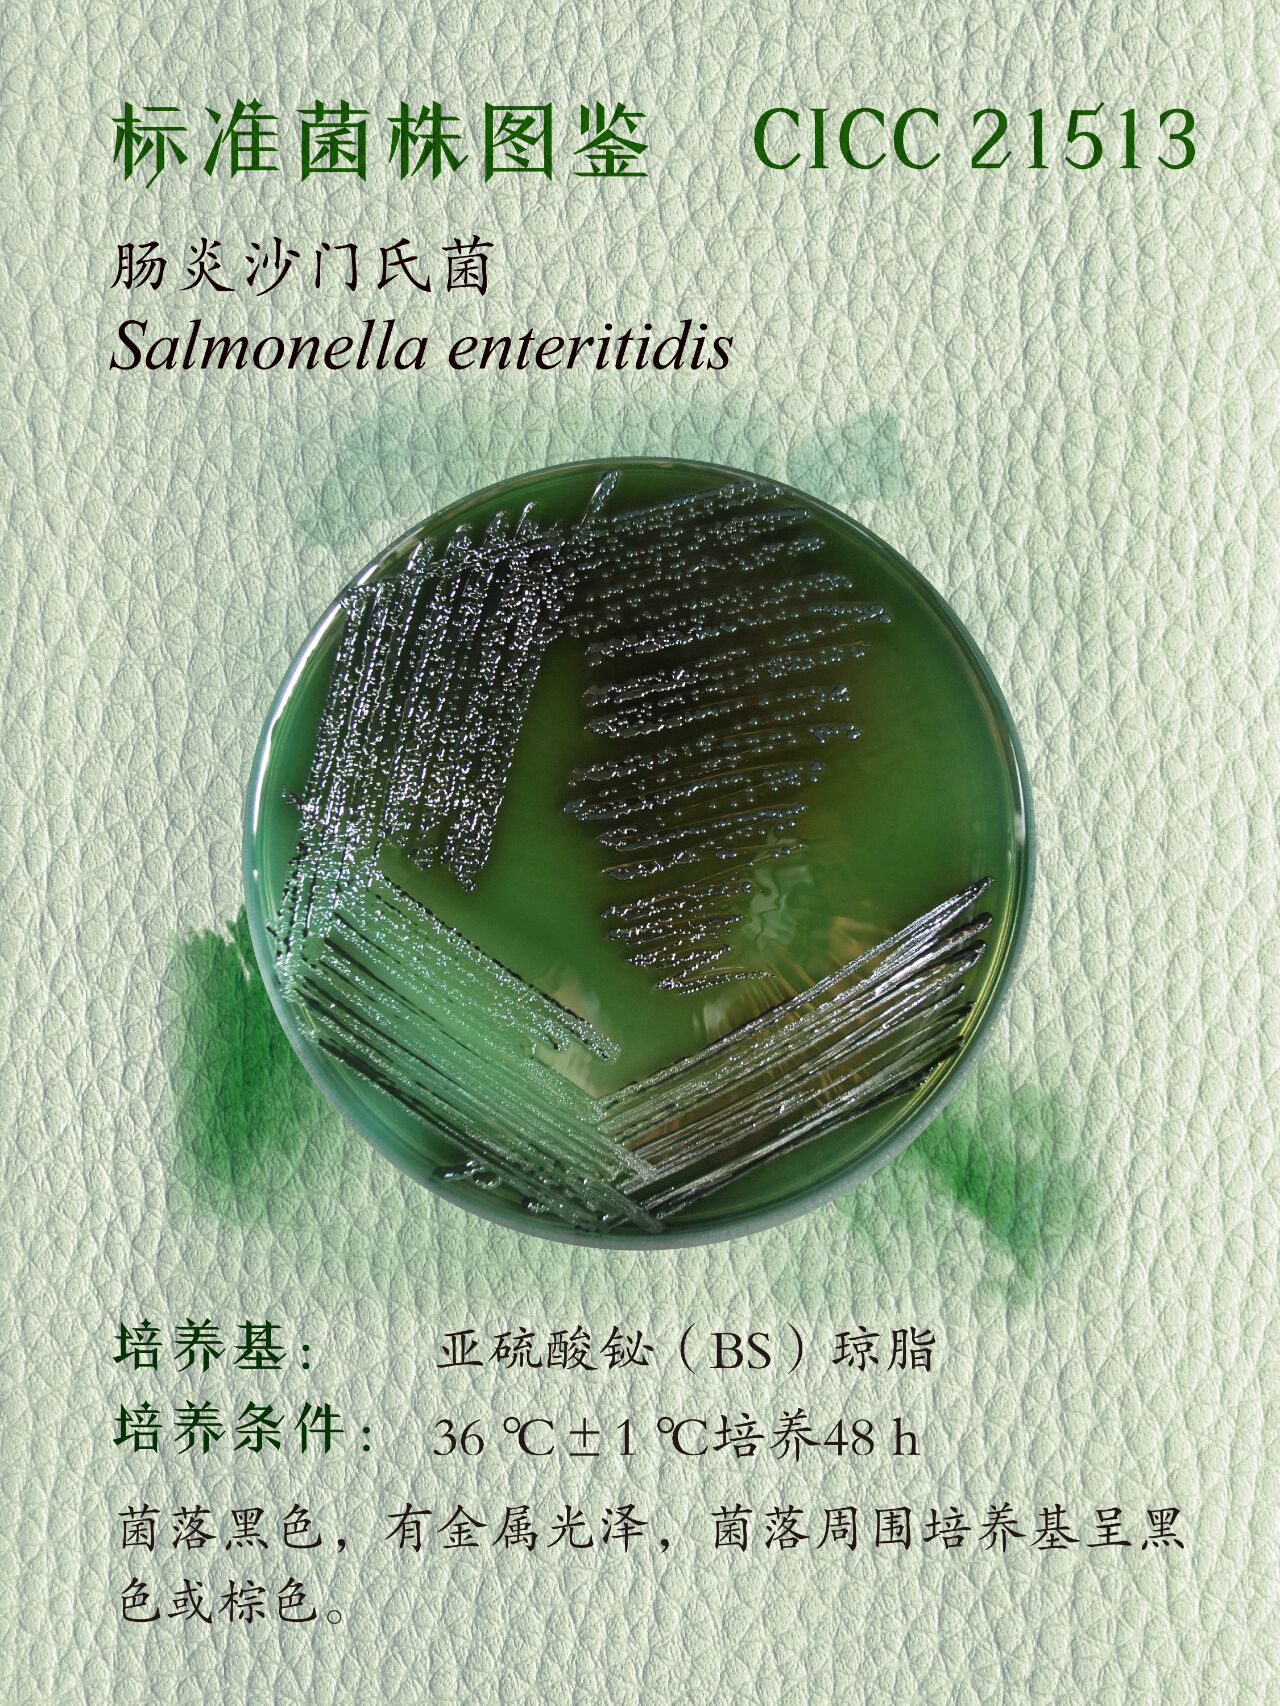
每日一菌丨肠炎沙门氏菌 cicc 21513 沙门氏菌属(salmonella)是一类

肠炎沙门氏菌

每日一菌丨肠炎沙门氏菌 cicc 21513 沙门氏菌属(salmonella)是一类
图片尺寸1280x1706
肠炎沙门氏菌
图片尺寸1200x807
肠炎沙门氏菌salmonel图片
图片尺寸450x338
血琼脂平板上的肠炎沙门氏菌菌落
图片尺寸1200x800
腹泻常见病原菌之沙门菌属.#科普一下 #微观世界 #实验室日 - 抖音
图片尺寸1440x1920![肠炎沙门氏菌肠炎亚种 mr595 [r595]bncc232404 菌种服务|伟业计量](https://i.ecywang.com/upload/1/img2.baidu.com/it/u=3427525538,1419922044&fm=253&fmt=auto&app=138&f=JPEG?w=339&h=197)
肠炎沙门氏菌肠炎亚种 mr595 [r595]bncc232404 菌种服务|伟业计量
图片尺寸358x208
细菌,盘子,血琼脂,大群动物,肠炎沙门氏菌
图片尺寸1200x800
鸡肠炎沙门氏菌病的症状图片有哪些?
图片尺寸394x275
鸡肠炎沙门氏菌病的症状图片有哪些?
图片尺寸392x266
怎么预防肠炎沙门氏菌
图片尺寸500x350
鸡肠炎沙门氏菌的分离和药物敏感性分析
图片尺寸300x299
兽医匪浅肠杆菌科沙门氏菌
图片尺寸1080x1425
什么是沙门氏菌,你了解沙门氏菌吗?生活中我们要怎样预防它呢
图片尺寸750x422
引起食物中毒最多的是鼠伤寒沙门菌,猪霍乱沙门菌,肠炎沙门菌和鸭
图片尺寸1080x1425
沙门氏菌小科普_污染_治疗_菌落
图片尺寸1080x389
【百益活菌】沙门氏菌/大肠杆菌/肠炎/鸽子拉稀(德国汉诺威)
图片尺寸730x965
"兽医"匪浅||肠杆菌科--沙门氏菌
图片尺寸1080x1425
沙门氏菌疫情引起的"巧克力恐慌"
图片尺寸1024x749
沙门氏菌
图片尺寸1080x1078
孩子发热,呕吐,拉肚子,元凶竟是"沙门氏菌"!
图片尺寸960x541



![肠炎沙门氏菌肠炎亚种 mr595 [r595]bncc232404 菌种服务|伟业计量](https://i.ecywang.com/upload/1/img2.baidu.com/it/u=3427525538,1419922044&fm=253&fmt=auto&app=138&f=JPEG?w=339&h=197)

![肠炎沙门氏菌肠炎亚种 mr595 [r595]bncc232404 菌种服务|伟业计量](https://beinabncc.oss-cn-beijing.aliyuncs.com/News/9226fe81a2f99f6ee253b362f6e29db5.png)










